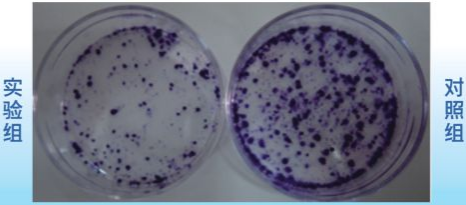
产品细节图片1

万千商家帮你免费找货
0 人在求购买到急需产品
- 详细信息
- 询价记录
- 技术资料
- 提供商:
深圳市拓普生物科技有限公司
- 服务名称:
克隆形成实验
服务介绍
细胞克隆形成率即细胞接种存活率,表示接种细胞后贴壁的细胞成活并形成克隆的数量。贴壁后的细胞不一定每个都能增殖和形成克隆,而形成克隆的细胞必为贴壁和有增殖活力的细胞。克隆形成率能够反应细胞群体依赖性和增殖能力两个重要性状。
服务内容
1) 取对数生长期的细胞,分别用0.25%胰酶消化并吹打成单细胞状态;
2) 将细胞悬液作梯度倍数稀释,每组细胞分别以每皿50、100、200个细胞的梯度密度分别接种含培养基的培养皿中,轻轻转动,使细胞分散均匀。将培养皿置于37℃、5% CO2培养箱中培养2~3周(根据细胞种类和生长状况);
3) 经常观察,当培养皿中出现肉眼可见的克隆时,终止培养。弃去上清液,用PBS小心浸洗2次。

细胞克隆形成率即细胞接种存活率,表示接种细胞后贴壁的细胞成活并形成克隆的数量。贴壁后的细胞不一定每个都能增殖和形成克隆,而形成克隆的细胞必为贴壁和有增殖活力的细胞。克隆形成率能够反应细胞群体依赖性和增殖能力两个重要性状。
服务内容
1) 取对数生长期的细胞,分别用0.25%胰酶消化并吹打成单细胞状态;
2) 将细胞悬液作梯度倍数稀释,每组细胞分别以每皿50、100、200个细胞的梯度密度分别接种含培养基的培养皿中,轻轻转动,使细胞分散均匀。将培养皿置于37℃、5% CO2培养箱中培养2~3周(根据细胞种类和生长状况);
3) 经常观察,当培养皿中出现肉眼可见的克隆时,终止培养。弃去上清液,用PBS小心浸洗2次。
风险提示:丁香通仅作为第三方平台,为商家信息发布提供平台空间。用户咨询产品时请注意保护个人信息及财产安全,合理判断,谨慎选购商品,商家和用户对交易行为负责。对于医疗器械类产品,请先查证核实企业经营资质和医疗器械产品注册证情况。
- 作者
- 内容
- 询问日期
 技术资料
技术资料暂无技术资料 索取技术资料
克隆形成实验
询价






